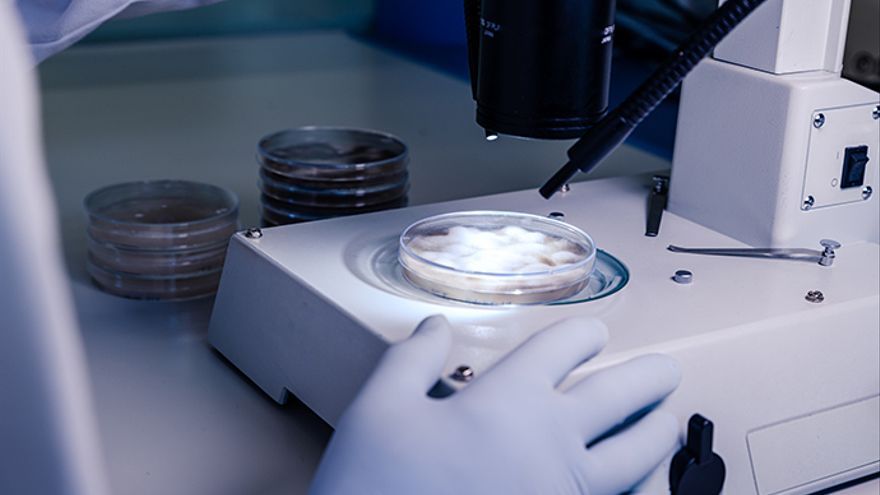
Una investigaci&oacute;n portuguesa ha desarrollado una nueva qu&iacute;mica a partir de la corteza del lapacho brasile&ntilde;o.

Un compuesto natural procedente de un árbol brasileño ha sido modificado para obtener un posible fármaco contra la leucemia mieloide aguda, señala un estudio que publica hoy Nature Chemistry.
Los compuestos naturales suelen tener un potencial terapéutico prometedor, pero su uso para tratar enfermedades se ve obstaculizado por su toxicidad o sus efectos no deseados.
Un equipo encabezado por científicos portugueses y con participación española ha desarrollado una nueva química sobre compuestos naturales derivados de la corteza del árbol del lapacho brasileño para obtener un agente terapéutico que podría ser eficaz contra esa enfermedad.
La leucemia mieloide aguda, la forma más común de leucemia aguda en adultos, es un cáncer agresivo con una tasa de supervivencia alrededor del 20 % después de cinco años y hay una alta incidencia de recaída.
El equipo utilizó en 2018 el aprendizaje automático para identificar el sitio objetivo de un compuesto de la corteza del árbol del lapacho que pertenece a la familia de las ortoquinonas, llamado Î-lapachona.
Estos compuestos son conocidos por su potencial para controlar el aumento anormal del número de células que caracteriza al cáncer, y son buenos candidatos para el tratamiento de la leucemia.
"El compuesto que exploramos en este estudio, llamado Î-lapachona, es un fármaco prometedor para tratar la leucemia, pero sus propiedades reactivas podrían tener efectos indeseables. En este trabajo, combinamos dos estrategias para minimizar los efectos negativos del compuesto", indicó Gonçalo Bernardes, líder del equipo y del Instituto de Medicina Molecular João Lobo Antunes.
El equipo, en el que participa Gonzalo Jiménez-Osés, del Centro español de Investigación Cooperativa en Biociencias en Bilbao, añadieron a ese compuesto un grupo químico que protege de sus propiedades reactivas, al actuar como una máscara que cubre la toxicidad del fármaco.
El compuesto modificado se une a una proteína, un anticuerpo, que lo lleva directamente al interior de las células cancerosas.
Las células cancerosas tienen ciertas marcas que las distinguen de las sanas, y en la leucemia mieloide aguda uno de estos marcadores específicos, llamado CD33, está presente en las células cancerosas.
El producto natural logrado por el equipo se unió a un anticuerpo, el cual se une específicamente a CD33, lo que permite al fármaco atravesar el organismo sin dañar ninguna célula sana.
Cuando el anticuerpo se encuentra con la célula cancerosa, se une al marcador CD33 y entrega el fármaco, momento en que se convertirá en su forma activa y tóxica, matando a la célula cancerosa.
Además del interés terapéutico de este enfoque para el tratamiento de la leucemia mieloide aguda, la química que se desarrolló puede utilizarse para otros compuestos naturales valiosos, permitiendo el uso de compuestos con potencial terapéutico que antes eran inapropiados para el uso medicinal.